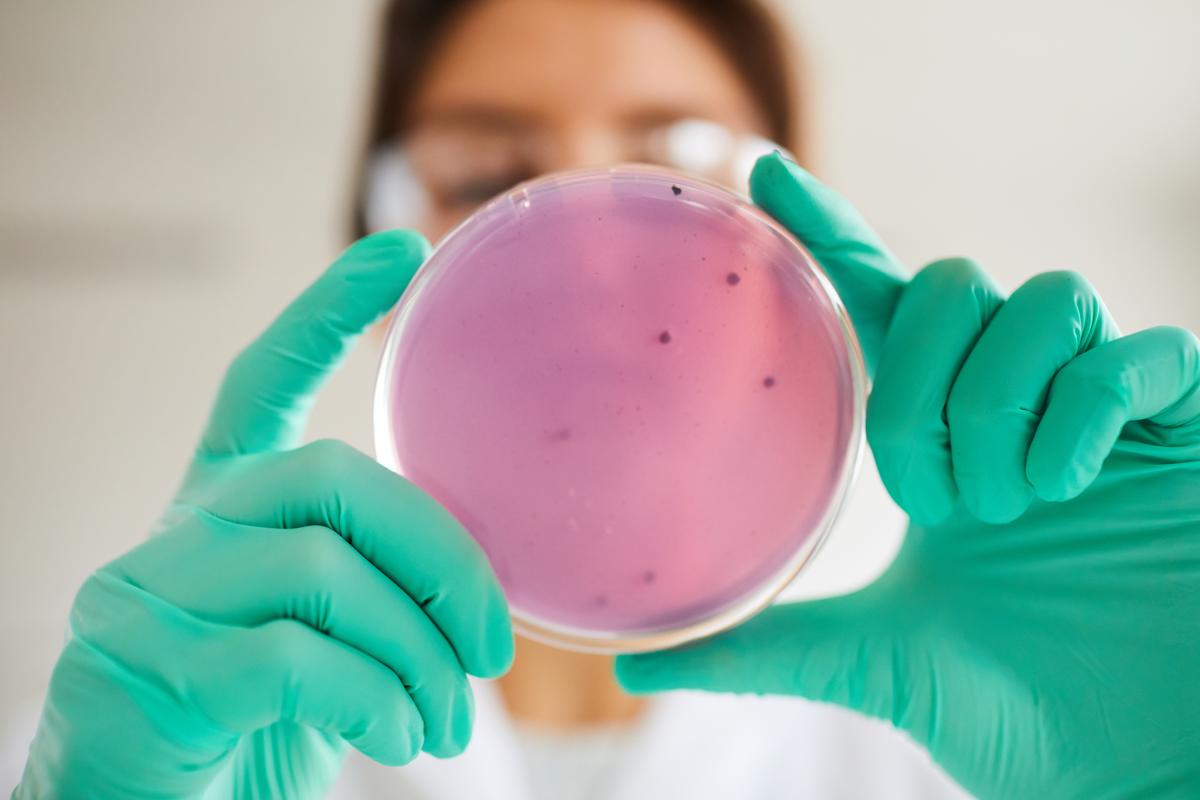
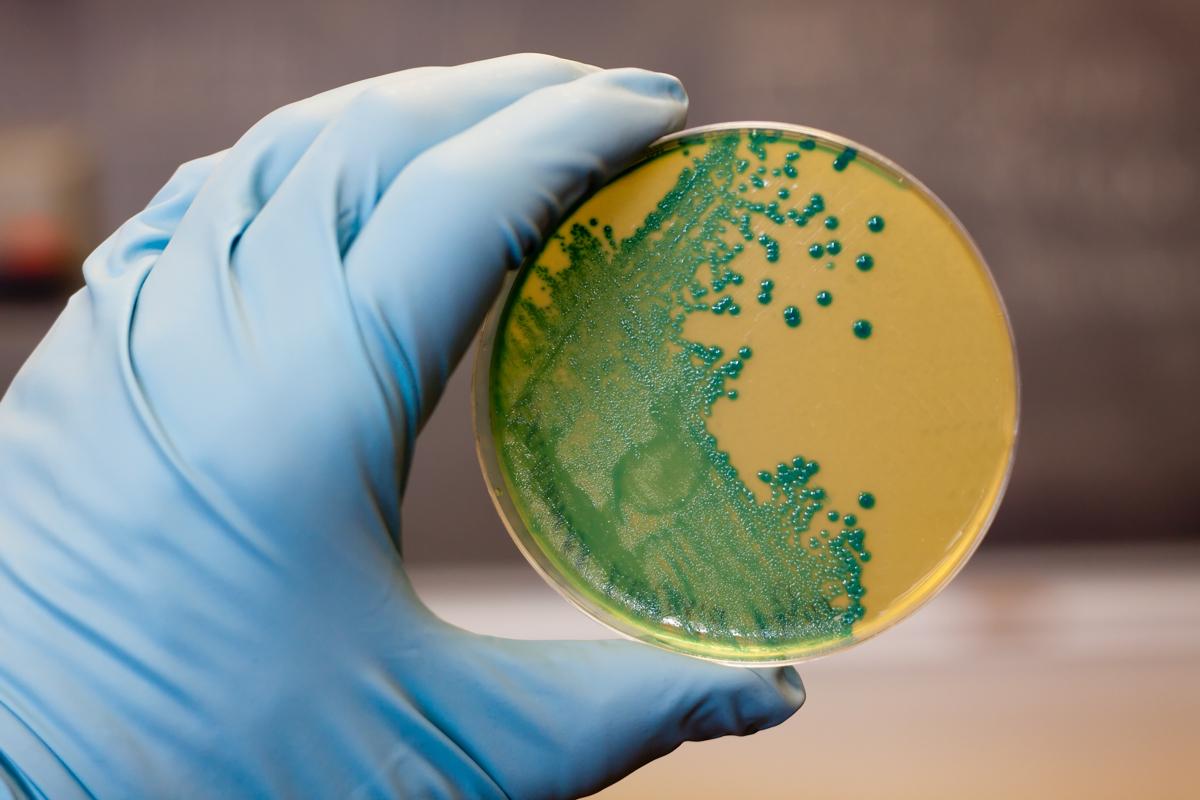

Gıda zehirlenmesi konusunda en sık duyduğumuz terim "salmonella" oldu. Bir tür bakteri olan salmonella; süt, çiğ tavuk ve yumurta ürünlerinde görülebiliyor. Peki, salmonella nasıl anlaşılır? Salmonella dıştan görünür mü, nasıl bulaşır? İşte, bilmeniz gerekenler...

Son günlerde artan gıda zehirlenmesi vakaları, kamuoyunda özellikle "salmonella" adıyla bilinen bakteriyi yeniden gündeme taşıdı.
Pek çok kişi, yaşanan zehirlenmelerin salmonella kaynaklı olup olmadığını merak ederken, uzmanlar iki kavramın sıkça karıştırıldığına dikkat çekiyor.
Gıda zehirlenmesi, farklı bakteri, parazit, virüs veya bozulmuş yiyeceklerin tüketilmesiyle oluşan geniş bir sağlık sorunu iken, salmonella, bu zehirlenmelere yol açabilen spesifik bir bakteri türü.
Özellikle çiğ veya az pişmiş tavuk, yumurta ve pastörize edilmemiş süt ürünleri salmonella bulaşma riskini artırıyor.
Peki; salmonella nasıl anlaşılır? Salmonella belirtileri nelerdir? Salmonella hakkında merak ettikleriniz...
SALMONELLA BAKTERİSİ NEDİR?
Salmonella, özellikle çiğ tavuk, yumurta, kırmızı et, pastörize edilmemiş süt ve kirlenmiş sebze–meyvelerde bulunabilen bakteri türüdür.
İnsana geçtiğinde "salmonelloz" adı verilen gıda zehirlenmesine yol açar.
Isıyla kolayca ölür, bu yüzden iyi pişirilmiş gıdalar genelde güvenlidir.
SALMONELLA NASIL BULAŞIR?
Salmonellayı gözle görülmez çünkü rengi yoktur, kokusu yoktur, tadı yoktur.
Etin dokusunu her zaman değiştirmez. Çiğ tavuğun görünümünden anlaşılmaz
Salmonella çoğu zaman bu şekilde yayılır:
Çiğ tavuk kesilen tahtada salata doğramak
Aynı bıçakla hem çiğ hem pişmiş yiyeceğe dokunmak
Çiğ tavuk suyunun buzdolabında diğer yiyeceklerle temas etmesi
SALMONELLA BELİRTİLERİ
Salmonella vücuda genelde 2–72 saat içinde etki eder. En sık görülen belirtiler:
1. Şiddetli ishal
Bazen kanlı olabilir.
2. Karın ağrısı ve kramp
Yoğun ve ani başlayan tipiktir.
3. Ateş
Genelde 38–40°C arasında olabilir.
4. Bulantı ve kusma
5. Halsizlik ve kas ağrıları
6. Dehidratasyon (su kaybı)
Sürekli ishal ve kusmaya bağlı olarak ortaya çıkar.








